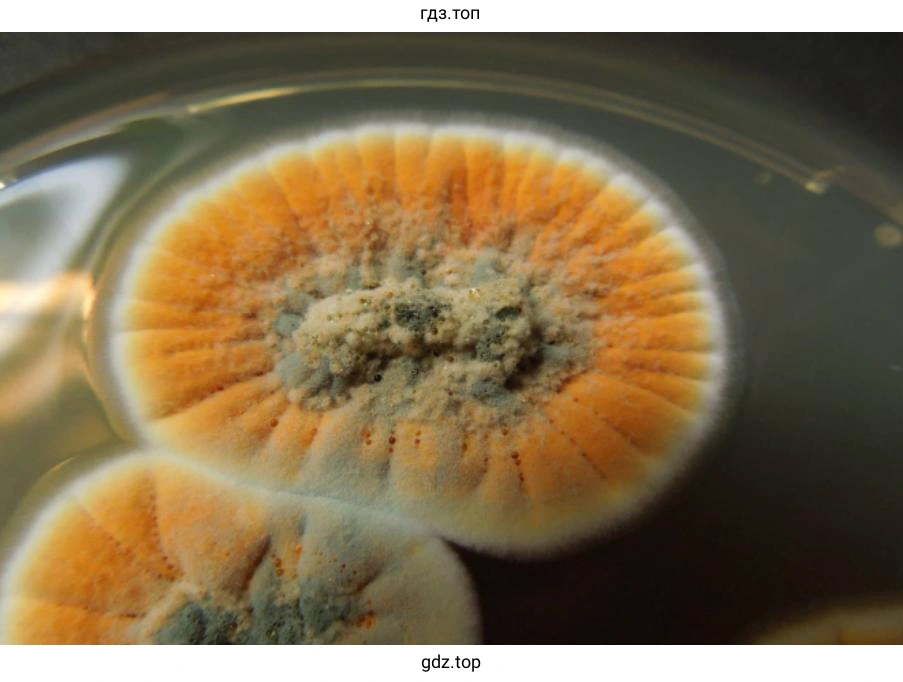

Страница 91 - гдз по биологии 5 класс учебник Пасечник, Суматохин

Авторы: Пасечник В. В., Суматохин С. В., Гапонюк З. Г., Швецов Г. Г.
Тип: Учебник
Серия: линия жизни
Издательство: Просвещение
Год издания: 2023 - 2025
Уровень обучения: базовый
Цвет обложки: белый, оранжевый с ракушкой
ISBN: 978-5-09-102242-1 (2023), 978-5-09-112161-2 (2024)
Допущено Министерством просвещения Российской Федерации
Популярные ГДЗ в 5 классе
Cтраница 91

Моя лаборатория (с. 91)
Условие. Моя лаборатория (с. 91)
скриншот условия

Страница 91. Моя лаборатория.
ВЫПОЛНИТЕ ЗАДАНИЯ
Задание 1. На основании материала параграфа и дополнительных источников информации подготовьте (по согласованию с учителем) сообщение и презентацию «Многообразие растений (животных, грибов) и их значение в природе и жизни человека». Выступите с сообщением в классе и обсудите его.
Задание 2. Познакомьтесь с положениями статьи Основные правила сбора грибов и строго их соблюдайте.
ЭТО ВАЖНО ЗНАТЬ
Основные правила сбора грибов
1. Собирайте только те грибы, о которых вы точно знаете, что они съедобны.
2. Никогда не употребляйте в пищу и не пробуйте грибы, в съедобности которых вы не уверены.
3. Никогда не собирайте, не ешьте и не пробуйте на вкус грибы, которые у основания ножки имеют клубневидное утолщение, окружённое оболочкой (как, например, у красного мухомора), — этот признак характерен для ядовитых грибов.
4. Не собирайте и не ешьте перезревшие, червивые и испорченные грибы.
5. При сборе шампиньонов обращайте внимание на цвет пластинок. Никогда не ешьте шампиньоны, имеющие белые пластинки. У настоящих шампиньонов пластинки быстро темнеют, а у смертельно ядовитой бледной поганки, по внешнему виду похожей на шампиньон, пластинки всегда белые.
6. Собирайте грибы в плетёные корзины, которые хорошо проветриваются, или в вёдра, но не в полиэтиленовые пакеты, так как в них они быстро могут испортиться.
7. Придя домой, переберите грибы, ещё раз внимательно осмотрите каждый из них, почистите и отварите.
8. Используйте грибы сразу после сбора. Их нельзя долго хранить сырыми, так как они быстро портятся.
9. Не выдёргивайте гриб из земли, лучше срезать его ножом или выкручивать аккуратно, слегка проворачивая за ножку и раскачивая так, чтобы не повредить грибницу. Отверстия, оставленные после сбора грибов, присыпьте мхом или другими элементами подстилки. Иначе другие грибы на этом месте могут уже не вырасти.
ЗАДАНИЕ ДЛЯ ЛЮБОЗНАТЕЛЬНЫХ
Учёные выяснили, что грибница некоторых грибов может расти со скоростью 5 мм в минуту. Считается, что это самый быстрый рост среди живых организмов. Посчитай, на сколько может вырасти грибница за сутки.
Решение. Моя лаборатория (с. 91)
скриншот решения







Моя лаборатория.
ВЫПОЛНИТЕ ЗАДАНИЯ
Задание 1.
"Многообразие грибов и их значение в природе и жизни человека"
Грибы — одно из самых загадочных царств живых организмов. В настоящее время известно около 100 тысяч видов грибов, но некоторые учёные разнообразие грибов оценивают гораздо выше - около 1, 5 миллиона. Грибы обитают везде: в почве, воде, воздухе, на поверхности и внутри живых организмов, в их выделениях и остатках.
Дрожжи — это одноклеточные микроскопические грибы. Они размножаются бесполым путём — почкованием.
Это большая группа грибов-сапротрофов насчитывает около 1,5 тысяч видов.
Дрожжи питаются глюкозой и сахарозой главным образом. В среде, содержащей кислород, дрожжи поглощают сахара и превращают их в воду и углекислый газ, а в бескислородных условиях окисляют их до этилового спирта и углекислого газа. Эту особенность обмена веществ дрожжей широко используют в изготовлении напитков (кваса, вина, пива) и хлебопечении. Приготовление дрожжевого хлеба — древнейшая технология, при которой в тесте, содержащем дрожжевые грибки, образуются пузырьки углекислого газа. Эти пузырьки увеличивают тесто в объёме, а после выпечки придают хлебобулочным изделиям пористость и мягкость.
Плесень можно встретить абсолютно везде: на продуктах питания, почве, стенах, старых книгах, одежде. Она выглядит как пушистый налёт разных цветов. Главные условия жизни для плесени: тепло, влага, органические вещества, которыми они питаются. Самыми распространёнными видами плесени являются мукор (головчатая плесень), который выглядит как белый пушистый налёт, на котором через некоторое время появляются и множатся чёрные точки, и пеницилл. Именно из пеницилла впервые был получен антибиотик, спасший миллионы жизней, - пенициллин.

Наиболее известны шляпочные грибы, обычные в лесных и луговых экосистемах. Они образуют плодовые тела, состоящие из шляпки и ножки.
По строению нижней части шляпки, несущей спороносный слой, шляпочные грибы делят на пластинчатые и трубчатые. У пластинчатых грибов снизу на шляпке видны радиально расходящиеся вертикальные пластинки, а у трубчатых — слой тесно расположенных тонких трубочек. На пластинках и внутри трубочек образуются многочисленные споры.
Плодовые тела некоторых грибов человек употребляет в пищу. Известно около 300 видов съедобных грибов. Наиболее популярны разводимые в культуре шампиньон двуспоровый и вёшенка устричная, а также дикорастущие — белый гриб, подберёзовик, груздь, лисичка, некоторые виды маслят, опят, сыроежек.
Многие шляпочные грибы (боровики, подберёзовики, маслята, мухоморы и другие) способны жить только в симбиозе с определёнными видами растений, образуя микоризу (грибокорень).

Существуют грибы, образующие плодовые тела, но не являющиеся шляпочными, то есть их плодовые тела не имеют шляпконожечного строения. Таковы, например, дождевики, у которых споры созревают внутри округлых плодовых тел, или сморчки со спороносным слоем, расположенным сверху, в морщинках и ячейках верхней части плодового тела.
Значение грибов в природе и жизни человека
В природе:
- Основные редуценты при разложении древесины.
- Пища для многих видов животных — начальные звенья детритных пищевых цепей.
- Симбионты растений.
- Паразитические виды грибов регулируют численность видов-хозяев.
Для человека
- Плодовые тела съедобных грибов — самостоятельный пищевой продукт с высокой питательной ценностью.
- Использование дрожжей в кормовой и пищевой промышленности — корм для животных, хлебопечение, пивоварение.
- Химическое сырьё для получения лимонной кислоты и ферментов (специальные линии дрожжей)
- Получение антибиотиков — например, пенициллина.
- Порча пищевых продуктов плесневыми грибами.
- Гниение материалов, прежде всего древесины, вызываемое трутовыми и плесневыми грибами. Повреждение промышленных изделий и материалов, произведений искусства (грибы используют в качестве субстрата бумагу, меховые и кожаные изделия, ткани, нефтепродукты, лаки, краски и т. д.)
- Заболевания растений, вред сельскому хозяйству (спорынья, головня, ржавчина)
- Заболевания человека и животных (микозы, аллергии).
- Отравления ядовитыми грибами.
Задание 2. Познакомьтесь с положениями статьи Основные правила сбора грибов и строго их соблюдайте.
ЭТО ВАЖНО ЗНАТЬ
Основные правила сбора грибов
1. Собирайте только те грибы, о которых вы точно знаете, что они съедобны.
2. Никогда не употребляйте в пищу и не пробуйте грибы, в съедобности которых вы не уверены.
3. Никогда не собирайте, не ешьте и не пробуйте на вкус грибы, которые у осно вания ножки имеют клубневидное утолщение, окружённое оболочкой (как, например, у красного мухомора), — этот признак характерен для ядовитых грибов.
4. Не собирайте и не ешьте перезревшие, червивые и испорченные грибы.
5. При сборе шампиньонов обращайте внимание на цвет пластинок. Никогда не ешьте шампиньоны, имеющие белые пластинки. У настоящих шампиньонов пластинки быстро темнеют, а у смертельно ядовитой бледной поганки, по внешнему виду похожей на шампиньон, пластинки всегда белые.
6. Собирайте грибы в плетёные корзины, которые хорошо проветриваются, или в вёдра, но не в полиэтиленовые пакеты, так как в них они быстро могут испортиться.
7. Придя домой, переберите грибы, ещё раз внимательно осмотрите каждый из них, почистите и отварите.
8. Используйте грибы сразу после сбора. Их нельзя долго хранить сырыми, так как они быстро портятся.
9. Не выдёргивайте гриб из земли, лучше срезать его ножом или выкручивать аккуратно, слегка проворачивая за ножку и раскачивая так, чтобы не повре дить грибницу. Отверстия, оставленные после сбора грибов, присыпьте мхом или другими элементами подстилки. Иначе другие грибы на этом месте могут уже не вырасти.
ЗАДАНИЕ ДЛЯ ЛЮБОЗНАТЕЛЬНЫХ
Вырастает в час:
5 (мм) х 60 (минут) = 300 мм
300 мм = 30 см
Вырастает в сутки:
30 (см) х 24 (часа) = 720 (см)
Помогло решение? Оставьте отзыв в комментариях ниже.